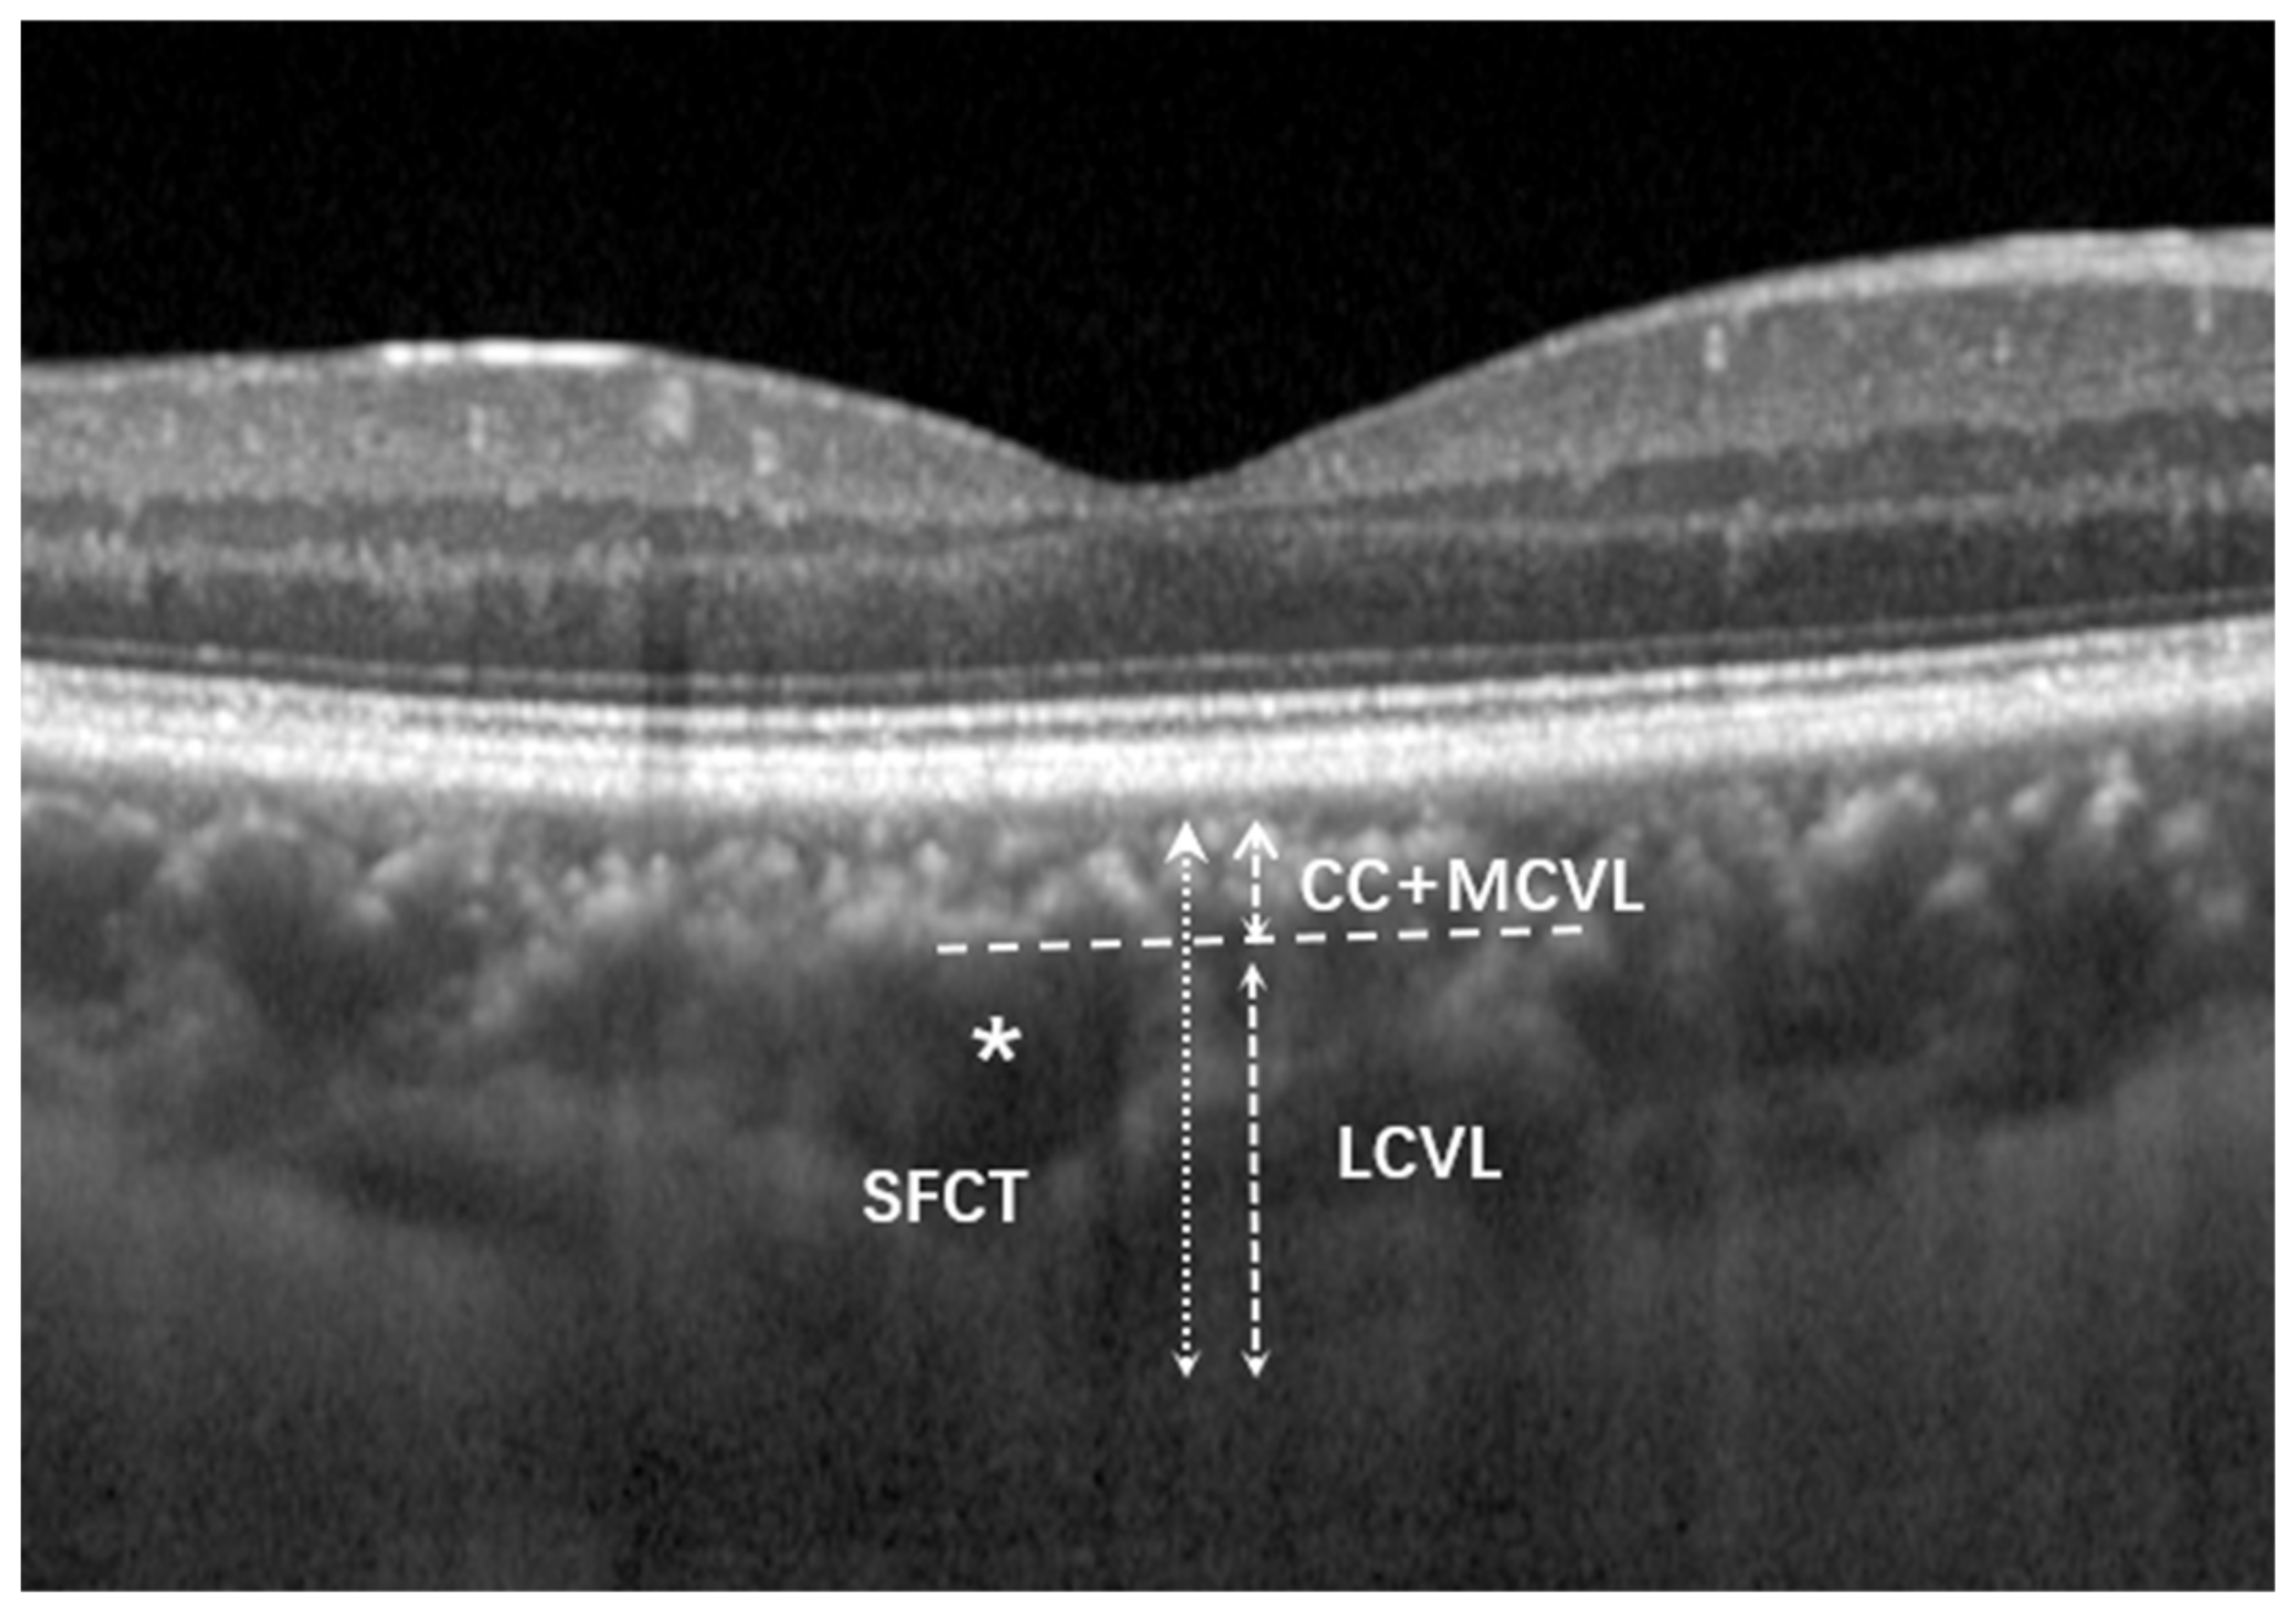
Jcm 12 01911 g002

Quantitative Assessment of Choroidal Thickness and Choroidal Vascular Features in Healthy Eyes Based on Image Binarization of EDI-OCT: A Single-Center Cross-Sectional Analysis in Chinese Population
Abstract
1. Introduction
2. Methods
2.1. Population
2.2. Data Collection
2.3. Quality Control of Images
2.4. Range of the Subfoveal Choroidal Area
2.5. Thickness Measurement of Each Choroidal Vascular Layer
2.6. Image Binarization and CVI Measurement
2.7. Interrater and Intrarater Agreement
3. Data Analysis
4. Results
4.1. Demographic Profile, Ocular and Choroidal Parameters of the Study Participants
4.2. Aging and Choroidal Parameter Changes
4.3. Factors Influencing CVI and LCVL/SFCT Measurements
4.4. Coefficient of Variation and Consistency Evaluation
5. Discussion
Author Contributions
Funding
Institutional Review Board Statement
Informed Consent Statement
Data Availability Statement
Conflicts of Interest
References
- Chung, S.E.; Kang, S.W.; Lee, J.H.; Kim, Y.T. Choroidal thickness in polypoidal choroidal vasculopathy and exudative age-related macular degeneration. Ophthalmology 2011, 118, 840–845. [Google Scholar] [CrossRef]
- Maruko, I.; Iida, T.; Sugano, Y.; Ojima, A.; Sekiryu, T. Subfoveal choroidal thickness in fellow eyes of patients with central serous chorioretinopathy. Retina 2011, 31, 1603–1608. [Google Scholar] [CrossRef]
- Han, X.; Du, N.N.; Li, S.; Diao, Z.L.; Fu, L.; Liu, W.H. Choroidal Vascularity Index Assessment: A Potential Noninvasive Technique for Diagnosing Diabetic Nephropathy. J. Ophthalmol. 2022, 2022, 3124746. [Google Scholar] [CrossRef]
- Dou, N.; Yu, S.; Tsui, C.-K.; Yang, B.; Lin, J.; Lu, X.; Xu, Y.; Wu, B.; Zhao, J.; Liang, X. Choroidal Vascularity Index as a Biomarker for Visual Response to Antivascular Endothelial Growth Factor Treatment in Diabetic Macular Edema. J. Diabetes Res. 2021, 2021, 3033219. [Google Scholar] [CrossRef]
- Koizumi, H.; Yamagishi, T.; Yamazaki, T.; Kawasaki, R.; Kinoshita, S. Subfoveal choroidal thickness in typical age-related macular degeneration and polypoidal choroidal vasculopathy. Graefes. Arch. Clin. Exp. Ophthalmol. 2011, 249, 1123–1128. [Google Scholar] [CrossRef]
- Imamura, Y.; Fujiwara, T.; Margolis, R.; Spaide, R.F. Enhanced depth imaging optical coherence tomography of the choroid in central serous chorioretinopathy. Retina 2009, 29, 1469–1473. [Google Scholar] [CrossRef]
- Lindberg, A.W.; Dahl, V.A.; Karlesand, I.; Rueløkke, L.L.; Malmqvist, L.; Hamann, S. Determination of peripapillary vessel density in optic disc drusen using EDI-OCT and OCT angiography. Exp. Eye Res. 2020, 197, 108123. [Google Scholar] [CrossRef] [PubMed]
- Sayin, N.; Kara, N.; Pirhan, D.; Vural, A.; Ersan, H.B.A.; Onal, H.; Cınar, S. Evaluation of subfoveal choroidal thickness in children with type 1 diabetes mellitus: An EDI-OCT study. Semin. Ophthalmol. 2014, 29, 27–31. [Google Scholar] [CrossRef]
- Fujiwara, T.; Imamura, Y.; Margolis, R.; Slakter, J.S.; Spaide, R.F. Enhanced depth imaging optical coherence tomography of the choroid in highly myopic eyes. Am. J. Ophthalmol. 2009, 148, 445–450. [Google Scholar] [CrossRef]
- Gupta, P.; Jing, T.; Marziliano, P.; Cheung, C.Y.; Baskaran, M.; Lamoureux, E.L.; Wong, T.Y.; Cheung, C.M.G.; Cheng, C.-Y. Distribution and determinants of choroidal thickness and volume using automated segmentation software in a population-based study. Am. J. Ophthalmol. 2015, 159, 293–301.e3. [Google Scholar] [CrossRef]
- Sansom, L.T.; Suter, C.A.; McKibbin, M. The association between systolic blood pressure, ocular perfusion pressure and subfoveal choroidal thickness in normal individuals. Acta Ophthalmol. 2016, 94, e157–e158. [Google Scholar] [CrossRef]
- Agrawal, R.; Gupta, P.; Tan, K.A.; Cheung, C.M.; Wong, T.Y.; Cheng, C.Y. Choroidal vascularity index as a measure of vascular status of the choroid: Measurements in healthy eyes from a population-based study. Sci. Rep. 2016, 6, 21090. [Google Scholar] [CrossRef] [PubMed]
- Ruiz-Medrano, J.; Flores-Moreno, I.; Peña-García, P.; Montero, J.A.; Feijoo, J.G.; Duker, J.S.; Ruiz-Moreno, J.M. Analysis of Age-Related Choroidal Layers Thinning in Healthy Eyes Using Swept-Source Optical Coherence Tomography. Retina 2017, 37, 1305–1313. [Google Scholar] [CrossRef] [PubMed]
- Branchini, L.A.; Adhi, M.; Regatieri, C.V.; Nandakumar, N.; Liu, J.J.; Laver, N.; Fujimoto, J.G.; Duker, J.S. Analysis of choroidal morphologic features and vasculature in healthy eyes using spectral-domain optical coherence tomography. Ophthalmology 2013, 120, 1901–1908. [Google Scholar] [CrossRef]
- Sonoda, S.; Sakamoto, T.; Yamashita, T.; Shirasawa, M.; Uchino, E.; Terasaki, H.; Tomita, M. Choroidal structure in normal eyes and after photodynamic therapy determined by binarization of optical coherence tomographic images. Investig. Ophthalmol. Vis. Sci. 2014, 55, 3893–3899, Erratum in Investig. Ophthalmol. Vis. Sci. 2014, 55, 4811–4812. [Google Scholar] [CrossRef]
- Agrawal, R.; Ding, J.; Sen, P.; Rousselot, A.; Chan, A.; Nivison-Smith, L.; Wei, X.; Mahajan, S.; Kim, R.; Mishra, C.; et al. Exploring choroidal angioarchitecture in health and disease using choroidal vascularity index. Prog. Retin. Eye Res. 2020, 77, 100829. [Google Scholar] [CrossRef]
- Betzler, B.K.; Ding, J.; Wei, X.; Lee, J.M.; Grewal, D.S.; Fekrat, S.; Sadda, S.R.; A Zarbin, M.; Agarwal, A.; Gupta, V.; et al. Choroidal vascularity index: A step towards software as a medical device. Br. J. Ophthalmol. 2022, 106, 149–155. [Google Scholar] [CrossRef]
- Alis, M.G.; Alis, A. Choroidal vascularity index in adults with different refractive status. Photodiagn. Photodyn. Ther. 2021, 36, 102533. [Google Scholar] [CrossRef] [PubMed]
- Velaga, S.B.; Nittala, M.G.; Vupparaboina, K.K.; Jana, S.; Chhablani, J.; Haines, J.; Pericak-Vance, M.A.; Stambolian, D.; Sadda, S.R. Choroidal Vascularity Index and Choroidal Thickness in Eyes with Reticular Pseudodrusen. Retina 2020, 40, 612–617. [Google Scholar] [CrossRef] [PubMed]
- Wu, H.; Zhang, G.; Shen, M.; Xu, R.; Wang, P.; Guan, Z.; Xie, Z.; Jin, Z.; Chen, S.; Mao, X.; et al. Assessment of Choroidal Vascularity and Choriocapillaris Blood Perfusion in Anisomyopic Adults by SS-OCT/OCTA. Investig. Ophthalmol. Vis. Sci. 2021, 62, 8. [Google Scholar] [CrossRef]
- Ugurlu, E.; Pekel, G.; Akbulut, S.; Cetin, N.; Durmus, S.; Altinisik, G. Choroidal vascularity index and thickness in sarcoidosis. Medicine 2022, 101, e28519. [Google Scholar] [CrossRef]
- Kongwattananon, W.; Kumar, A.; Oyeniran, E.; Sen, H.N.; Kodati, S. Changes in Choroidal Vascularity Index (CVI) in Intermediate Uveitis. Transl. Vis. Sci. Technol. 2021, 10, 33. [Google Scholar] [CrossRef] [PubMed]
- Demirel, S.; Yanık, Ö.; Özcan, G.; Batıoğlu, F.; Özmert, E. A comparative study on the choroidal vascularity index and the determination of cut-off values in the pachychoroid spectrum diseases. Jpn. J. Ophthalmol. 2021, 65, 482–491. [Google Scholar] [CrossRef] [PubMed]
- Sonoda, S.; Sakamoto, T.; Yamashita, T.; Uchino, E.; Kawano, H.; Yoshihara, N.; Terasaki, H.; Shirasawa, M.; Tomita, M.; Ishibashi, T. Luminal and stromal areas of choroid determined by binarization method of optical coherence tomographic images. Am. J. Ophthalmol. 2015, 159, 1123–1131.e1. [Google Scholar] [CrossRef] [PubMed]
- Ruiz-Medrano, J.; Flores-Moreno, I.; Peña-García, P.; Montero, J.A.; Duker, J.S.; Ruiz-Moreno, J.M. Asymmetry in Macular Choroidal Thickness Profile between Both Eyes in a Healthy Population Measured by Swept-Source Optical Coherence Tomography. Retina 2015, 35, 2067–2073. [Google Scholar] [CrossRef] [PubMed]
- Chirco, K.R.; Sohn, E.H.; Stone, E.M.; Tucker, B.A.; Mullins, R.F. Structural and molecular changes in the aging choroid: Implications for age-related macular degeneration. Eye 2017, 31, 10–25. [Google Scholar] [CrossRef] [PubMed]
- Mullins, R.F.; Johnson, M.N.; Faidley, E.A.; Skeie, J.M.; Huang, J. Choriocapillaris vascular dropout related to density of drusen in human eyes with early age-related macular degeneration. Investig. Ophthalmol. Vis. Sci. 2011, 52, 1606–1612. [Google Scholar] [CrossRef]
- Wakatsuki, Y.; Shinojima, A.; Kawamura, A.; Yuzawa, M. Correlation of Aging and Segmental Choroidal Thickness Measurement using Swept Source Optical Coherence Tomography in Healthy Eyes. PLoS ONE 2015, 10, e0144156. [Google Scholar] [CrossRef]
- Leo, F.; Suvorava, T.; Heuser, S.K.; Li, J.; LoBue, A.; Barbarino, F.; Piragine, E.; Schneckmann, R.; Hutzler, B.; Good, M.E.; et al. Red Blood Cell and Endothelial eNOS Independently Regulate Circulating Nitric Oxide Metabolites and Blood Pressure. Circulation 2021, 144, 870–889. [Google Scholar] [CrossRef]
- Toda, N. Age-related changes in endothelial function and blood flow regulation. Pharmacol. Ther. 2012, 133, 159–176. [Google Scholar] [CrossRef]
- Koçak, N.; Subaşı, M.; Yeter, V. Effects of age and binarising area on choroidal vascularity index in healthy eyes: An optical coherence tomography study. Int. Ophthalmol. 2021, 41, 825–834. [Google Scholar] [CrossRef] [PubMed]

| Sample Size | Total | Male | Female | p-Value |
|---|---|---|---|---|
| n = 1566 | n = 768 | n = 798 | ||
| Age, years | 43.62 ± 23.29 | 46.58 ± 25.81 | 46.80 ± 25.25 | 0.886 |
| BMI, kg/m2 | 23.75 ± 5.72 | 23.49 ± 5.60 | 23.87 ± 5.77 | 0.186 |
| Systolic blood pressure, mmHg | 105.21 ± 13.63 | 105.85 ± 12.98 | 104.92 ± 13.71 | 0.169 |
| Diastolic blood pressure, mmHg | 67.27 ± 10.85 | 68.07 ± 11.02 | 67.13 ± 10.42 | 0.083 |
| Fasting blood glucose, mmol/L | 4.38 ± 1.35 | 4.43 ± 0.87 | 4.37 ± 1.52 | 0.340 |
| Ocular axis, mm | 22.91 ± 1.02 | 22.85 ± 2.13 | 22.92 ± 1.84 | 0.486 |
| IOP, mmHg | 13.69 ± 2.37 | 13.59 ± 2.43 | 13.71 ± 1.95 | 0.280 |
| TCA, mm2 | 0.81 ± 0.20 | 0.81 ± 0.20 | 0.82 ± 0.20 | 0.516 |
| SA, mm2 | 0.25 ± 0.07 | 0.25 ± 0.07 | 0.26 ± 0.07 | 0.709 |
| LA, mm2 | 0.56 ± 0.14 | 0.56 ± 0.14 | 0.56 ± 0.14 | 0.449 |
| CVI (LA/TCA), % | 68.68 ± 2.97 | 68.60 ± 2.97 | 68.76 ± 2.97 | 0.306 |
| SFCT, μm | 271.64 ± 67.35 | 271.50 ± 70.60 | 271.78 ± 64.12 | 0.934 |
| CC+MCVL thickness, μm | 62.60 ± 20.62 | 61.97 ± 20.75 | 63.21 ± 20.49 | 0.234 |
| LCVL thickness, μm | 209.04 ± 55.74 | 209.53 ± 58.07 | 208.57 ± 53.44 | 0.733 |
| LCVL/SFCT, % | 76.81 ± 5.91 | 77.03 ± 5.68 | 76.6 ± 6.12 | 0.145 |
| n | TCA, mm2 | SA, mm2 | LA, mm2 | CVI (LA/TCA), % | |
|---|---|---|---|---|---|
| 0–10 years old group | 115 | 0.75 ± 0.17 | 0.21 ± 0.06 | 0.54 ± 0.12 | 72.42 ± 2.10 |
| 11–20 years old group | 163 | 0.80 ± 0.17 | 0.23 ± 0.050 | 0.56 ± 0.12 | 71.41 ± 1.58 |
| 21–30 years old group | 255 | 0.82 ± 0.21 | 0.24 ± 0.07 | 0.57 ± 0.15 | 70.29 ± 1.84 |
| 31–40 years old group | 228 | 0.85 ± 0.18 | 0.26 ± 0.05 | 0.59 ± 0.13 | 69.29 ± 1.87 |
| 41–50 years old group | 212 | 0.81 ± 0.19 | 0.25 ± 0.06 | 0.55 ± 0.13 | 68.73 ± 1.66 |
| 51–60 years old group | 205 | 0.84 ± 0.22 | 0.27 ± 0.07 | 0.57 ± 0.15 | 67.59 ± 1.87 |
| 61–70 years old group | 133 | 0.84 ± 0.20 | 0.28 ± 0.07 | 0.56 ± 0.13 | 66.71 ± 1.63 |
| 71–80 years old group | 129 | 0.77 ± 0.20 | 0.27 ± 0.07 | 0.50 ± 0.13 | 65.21 ± 2.03 |
| >80 years old group | 126 | 0.80 ± 0.24 | 0.28 ± 0.09 | 0.52 ± 0.15 | 64.68 ± 3.12 |
| p-value | <0.001 * | <0.001 * | <0.001 * | <0.001 * |
| n | SFCT, μm | CC+MCVL Thickness, μm | LCVL Thickness, μm | LCVL/SFCT, % | |
|---|---|---|---|---|---|
| 0–10 years old group | 115 | 263.07 ± 50.41 | 73.20 ± 19.82 | 189.87 ± 42.66 | 71.90 ± 6.78 |
| 11–20 years old group | 163 | 280.59 ± 44.23 | 75.37 ± 18.69 | 205.23 ± 38.98 | 73.02 ± 5.97 |
| 21–30 years old group | 255 | 280.21 ± 76.75 | 70.65 ± 24.82 | 209.56 ± 64.46 | 74.50 ± 7.43 |
| 31–40 years old group | 228 | 277.79 ± 91.75 | 67.21 ± 22.90 | 210.58 ± 74.69 | 75.35 ± 5.74 |
| 41–50 years old group | 212 | 274.96 ± 59.10 | 61.32 ± 13.56 | 213.65 ± 47.54 | 77.61 ± 2.39 |
| 51–60 years old group | 205 | 268.89 ± 58.35 | 57.68 ± 13.07 | 211.20 ± 47.36 | 78.43 ± 2.81 |
| 61–70 years old group | 133 | 266.26 ± 56.78 | 54.23 ± 12.22 | 212.04 ± 45.94 | 79.60 ± 1.89 |
| 71–80 years old group | 129 | 258.67 ± 69.53 | 47.84 ± 15.78 | 210.83 ± 58.20 | 81.35 ± 3.69 |
| >80 years old group | 126 | 257.24 ± 63.59 | 45.89 ± 14.05 | 211.35 ± 55.69 | 81.98 ± 4.34 |
| p-value | 0.003 * | <0.001 * | 0.029 * | <0.001 * |
| Univariate | Multivariate | |||||
|---|---|---|---|---|---|---|
| Unstandardized β | Standardized b | p-Value | Unstandardized β | Standardized b | p-Value | |
| Age/10 years | 0.951 | −0.745 | <0.001 | −0.084 | −0.065 | <0.001 |
| Sex | −0.003 | −0.021 | 0.869 | / | / | / |
| BMI | −0.005 | −0.290 | 0.050 | −0.003 | −0.164 | 0.190 |
| Diastolic blood pressure | −0.001 | −0.032 | 0.735 | / | / | / |
| Systolic blood pressure | −0.000 | −0.016 | 0.893 | / | / | / |
| Fasting blood glucose | −0.001 | −0.036 | 0.643 | / | / | / |
| Ocular axis | −0.003 | −0.138 | 0.040 | −0.001 | −0.099 | 0.132 |
| IOP | −0.001 | −0.034 | 0.704 | / | / | / |
| TCA mm2 | −0.011 | −0.009 | 0.756 | / | / | / |
| SA, mm2 | −0.029 | 0.403 | <0.001 | −0.013 | −0.354 | 0.231 |
| LA, mm2 | 0.017 | 0.312 | <0.001 | 36.830 | 1.712 | <0.001 |
| SFCT, μm | 0.009 | −0.019 | 0.752 | / | / | / |
| CC+MCVL thickness, μm | −0.003 | 0.462 | 0.011 | −0.003 | −0.338 | 0.160 |
| LCVL thickness, μm | 0.002 | 0.534 | <0.001 | 0.003 | −0.058 | 0.011 |
| LCVL/SFCT | 0.000 | 0.248 | <0.001 | −0.034 | −0.068 | 0.012 |
| Univariate | Multivariate | |||||
|---|---|---|---|---|---|---|
| Unstandardized β | Standardized b | p-Value | Unstandardized β | Standardized b | p-Value | |
| Age, /10 years | −1.302 | 0.513 | <0.001 | 0.850 | 0.062 | 0.013 |
| Sex | −0.003 | −0.021 | 0.869 | / | / | / |
| Ocular axis | −0.003 | −0.138 | 0.03 | −0.003 | −0.093 | 0.193 |
| IOP | −0.001 | −0.034 | 0.704 | / | / | / |
| BMI | −0.002 | −0.790 | 0.562 | / | / | / |
| Diastolic blood pressure | −0.002 | −0.027 | 0.795 | / | / | / |
| Systolic blood pressure | −0.001 | −0.019 | 0.587 | / | / | / |
| Fasting blood glucose | −0.001 | −0.006 | 0.685 | / | / | / |
| TCA mm2 | −0.003 | −0.027 | <0.001 | −0.002 | −0.084 | 0.024 |
| SA, mm2 | −0.002 | −0.585 | <0.001 | −0.001 | −0.503 | 0.374 |
| LA, mm2 | 0.001 | 0.297 | 0.034 | 0.000 | −0.447 | 0.001 |
| SFCT, μm | 0.002 | −0.019 | <0.001 | −0.002 | −0.094 | <0.001 |
| CC+MCVL thickness, μm | −0.001 | −0.02 | 0.538 | / | / | / |
| LCVL thickness, μm | 0.003 | 0.032 | <0.001 | 0.003 | −0.047 | <0.001 |
| CVI | 0.004 | 0.302 | <0.001 | 0.003 | −0.364 | 0.001 |
| Interrater Reliability | Intrarater Reliability | |||
|---|---|---|---|---|
| ICC | 95% Confidence Interval | ICC | 95% Confidence Interval | |
| CVI | 0.987 | 0.967–0.991 | 0.987 | 0.982–0.995 |
| SFCT | 0.962 | 0.937–0.982 | 0.964 | 0.946–0.975 |
Disclaimer/Publisher’s Note: The statements, opinions and data contained in all publications are solely those of the individual author(s) and contributor(s) and not of MDPI and/or the editor(s). MDPI and/or the editor(s) disclaim responsibility for any injury to people or property resulting from any ideas, methods, instructions or products referred to in the content. |
© 2023 by the authors. Licensee MDPI, Basel, Switzerland. This article is an open access article distributed under the terms and conditions of the Creative Commons Attribution (CC BY) license (https://creativecommons.org/licenses/by/4.0/).
Share and Cite
Wang, L.; Wang, W.; Zhou, Z.; Wang, H.; Chakravarthy, U.; Peto, T.; Casalino, G.; Wang, K.; Li, S. Quantitative Assessment of Choroidal Thickness and Choroidal Vascular Features in Healthy Eyes Based on Image Binarization of EDI-OCT: A Single-Center Cross-Sectional Analysis in Chinese Population. J. Clin. Med. 2023, 12, 1911. https://doi.org/10.3390/jcm12051911
Wang L, Wang W, Zhou Z, Wang H, Chakravarthy U, Peto T, Casalino G, Wang K, Li S. Quantitative Assessment of Choroidal Thickness and Choroidal Vascular Features in Healthy Eyes Based on Image Binarization of EDI-OCT: A Single-Center Cross-Sectional Analysis in Chinese Population. Journal of Clinical Medicine. 2023; 12(5):1911. https://doi.org/10.3390/jcm12051911
Chicago/Turabian StyleWang, Luping, Wei Wang, Zhuohua Zhou, Hao Wang, Usha Chakravarthy, Tunde Peto, Giuseppe Casalino, Kang Wang, and Shuang Li. 2023. "Quantitative Assessment of Choroidal Thickness and Choroidal Vascular Features in Healthy Eyes Based on Image Binarization of EDI-OCT: A Single-Center Cross-Sectional Analysis in Chinese Population" Journal of Clinical Medicine 12, no. 5: 1911. https://doi.org/10.3390/jcm12051911
APA StyleWang, L., Wang, W., Zhou, Z., Wang, H., Chakravarthy, U., Peto, T., Casalino, G., Wang, K., & Li, S. (2023). Quantitative Assessment of Choroidal Thickness and Choroidal Vascular Features in Healthy Eyes Based on Image Binarization of EDI-OCT: A Single-Center Cross-Sectional Analysis in Chinese Population. Journal of Clinical Medicine, 12(5), 1911. https://doi.org/10.3390/jcm12051911

